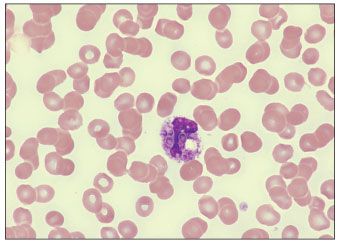

Hemophagocytic syndrome is a macrophage disorder that may develop as a result of immunological activation, such as that seen in severe infection.
Hemophagocytic syndrome is an uncommon disorder of the mononuclear phagocytic system characterized by prominent hemophagocytosis in the bone marrow and a constellation of associated clinical findings: fever, hepatosplenomegaly, pancytopenia, liver dysfunction, disseminated intravascular coagulation, and elevated ferritin levels. Since the initial cases described more than 25 years ago,1 2 types of hemophagocytic syndrome have been reported in the literature: the primary (familial) type and the secondary (reactive) type. The latter type has been attributed to autoimmune disorders (eg, systemic lupus erythematosus); hematological malignancies (eg, Kaposi sarcoma, T- and B-cell lymphomas); and a variety of infectious agents, including viruses (Epstein-Barr virus, Cytomegalovirus, Parvovirus B19); bacteria (Mycobacterium tuberculosis, Mycoplasma, Coxiella); fungi (Aspergillus, Cryptococcus); and parasites (Plasmodium species,Toxoplasma,Babesia). The hemophagocytic syndrome has also been described in patients with HIV infection and in those with AIDS-associated opportunistic infections.
CASE SUMMARY
A 61-year-old Hispanic man presented to the emergency department with a 6-month history of generalized fatigue, a 3-month history of right thoracic pain, and several days of fevers. The patient denied any past medical history. He was admitted for further evaluation. Originally from Mexico, he had immigrated to Los Angeles 5 years ago and was currently homeless.
The patient was found to be poorly responsive to questions and commands, febrile (temperature of 38.4°C [101.2°F]), and hypotensive (blood pressure, 90/56 mm Hg). Blood chemistries showed elevated levels of lactate dehydrogenase (LDH) (1645 U/L; normal, 90 to 220), ferritin (greater than 3000 µg/L; normal, 30 to 330), D-dimer (greater than 9999 µg/L; normal, 0 to 200), and aspartate aminotransferase (203 U/L; normal, 10 to 40). CT of the abdomen showed moderate splenomegaly. A complete blood cell count demonstrated a profound pancytopenia: white blood cell count, 1600/µL (normal, 3700 to 10,300), with 97% neutrophils, 1% lymphocytes, and 2% eosinophils; hemoglobin level, 7.9 g/dL (normal, 13.8 to 16.9); and platelet count, 20,000/µL (normal, 145,000 to 340,000).
The peripheral blood smear obtained on admission showed reactive neutrophilia with toxic granulation, rouleaux formation, and intracellular yeast forms consistent with Histoplasma capsulatum (Figure 1). Peripheral blood cultures yielded growth of H capsulatum. With a CD4+ cell count of 4/µL, the patient was given a diagnosis of AIDS. A chest radiograph showed a right lower lobe infiltrate, and sputum cultures were positive for M tuberculosis and negative for fungal organisms.
Figure 1.Peripheral blood smear showing reactive neutrophilia with toxic granulation, rouleaux formation, and intracellular yeast forms consistent with Histoplasma capsulatum (hematoxylin-eosin, original magnification ×100). (Illustration courtesy of the department of hematology-pathology at the Keck School of Medicine at the University of Southern California.)
The patient was admitted and treated with intravenous dopamine for hemodynamic support of his hypotension, along with antituberculosis medications and amphotericin B. His condition remained unchanged for the first few days. A bone marrow biopsy was performed on hospital day 8 because of an increasing need for blood product transfusions. The bone marrow biopsy specimen stained with Gomori methenamine-silver revealed extensive involvement by Histoplasma (Figure 2), as well as ingestion of hematopoietic cells by phagocytic histiocytes (Figure 3)-findings consistent with the hemophagocytic syndrome.

Figure 2. Bone marrow biopsy revealing extensive involvement by Histoplasma capsulatum (Gomori methenamine-silver, original magnification ×400). (Illustration courtesy of the department of hematology-pathology at the Keck School of Medicine at the University of Southern California.)

Figure 3.Bone marrow biopsy aspirate showing a phagocytic histiocyte with ingested Histoplasma yeast bodies and self-hematopoietic cells-findings that are consistent with the hemophagocytic syndrome (hematoxylin-eosin, original magnification ×400). (Illustration courtesy of the department of hematology-pathology at the Keck School of Medicine at the University of Southern California.)
The patient remained in the ICU for 3 weeks, with a gradual declining need for dopamine support and transfusions of blood products and with no other significant events. After 6 weeks of treatment with amphotericin B and antituberculosis medications, the patient was doing well. Dopamine treatment was stopped; the patient was afebrile and his hematologic profile was improving. He was discharged on a regimen of itraconazole and antituberculosis medications.
DISCUSSION
The hemophagocytic syndrome is a reactive disorder of mononuclear cells, characterized by exaggerated histiocytic proliferation and activation with marked hemophagocytosis. It is believed that hyperactivation of the immune system results in an excess of cytokine expression, which, driven by the underlying cause, activates macrophages that subsequently phagocytize hematopoietic elements (red blood cells, white blood cells, and platelets) in the bone marrow. Diagnosis of the hemophagocytic syndrome is based on both histopathological and clinical findings. Diagnostic criteria have been proposed by the Familial Hemophagocytic Lymphohistiocytosis Study Group of the Histiocyte Society2:
• Clinical criteria: fever, splenomegaly, cytopenia affecting 2 of 3 cell lines, and hypertriglyceridemia.
• Histological criteria: hemophagocytosis in bone marrow, spleen, or lymph node.
The hemophagocytic syndrome is an uncommon condition without reliable incidence rates because of the necessity of a bone marrow examination to firmly establish the diagnosis. It is likely that the hemophagocytic syndrome is underdiagnosed, and cases that are identified are in the subset of patients with more advanced disease. When this syndrome is encountered, it is important to exclude any underlying conditions that may be reversible.
Reactive hemophagocytic syndrome categorically carries a high mortality, ranging from 52% to 74% at 1 year.3-6 Most cases of infection-associated hemophagocytic syndrome described in the literature also document poor outcomes for patients.4,7 Predictors of a poor outcome have been shown to be age older than 30 years, the presence of disseminated intravascular coagulation, elevated ferritin level, and anemia with accompanying thrombocytopenia.4 There are, however, a few case reports of successful outcomes.7 Treatment strategies for the hemophagocytic syndrome are not well described, but addressing the offending agent is an important treatment strategy. Corticosteroids or other immunomodulators used to suppress the cytokine storm that drives the hemophagocytic syndrome have shown mixed results and are currently not advocated.
HIV infection, alone or concurrently with other infections, is a cause of the hemophagocytic syndrome.3,8 A variety of opportunistic conditions have been described with HIV-associated hemophagocytic syndrome: Cytomegalovirus infection, Cryptococcus infection, Kaposi sarcoma, tuberculosis, toxoplasmosis, varicella, Pneumocystis jiroveci (formerly P carinii) pneumonia, lymphomas, and Mycobacterium avium complex infection. HIV-associated hemophagocytic syndrome has also been seen in patients with low CD4+ cell counts without obvious comorbidities.5 Early identification and treatment of any underlying opportunistic infection with or without concomitant use of antiretroviral therapy may help in recovery. Although nonspecific, laboratory findings of dramatic hyperferritinemia and elevated serum LDH levels in HIV-infected patients should provide clues to a diagnosis of reactive hemophagocytic syndrome.9
Unfortunately, many cases of HIV-associated hemophagocytic syndrome are aggressive and often fatal. The CD4+ cell count seems to be a factor of prognosis: patients with lower CD4+ cell counts do poorly. In a review of the hemophagocytic syndrome in 26 persons with HIV/AIDS, 20 (77%) died. For patients with a poor outcome whose CD4+ cell counts were provided, the majority (11 of 13) had counts less than 100/µL; their mean CD4+ cell count was 115/µL. Of the 6 patients who survived, 3 had CD4+ cell counts greater than 500/µL and 3 had no CD4 count reported.3
The rarity of HIV-associated hemophagocytic syndrome and the associated high mortality have made it difficult to interpret whether initiating antiretroviral therapy provides any advantage. However, with our understanding of the underlying biological mechanism of disease, suppressing this cytokine storm produced by the virus should theoretically provide some benefit.
Histoplasmosis, an opportunistic fungal infection commonly seen in patients with AIDS, is transmitted by inhalation of fungal spores. It is predominantly reported in areas of North and Central America, where Histoplasma is endemic. The diagnosis of histoplasmosis is usually made on the basis of blood or tissue cultures positive for Histoplasma, detection of Histoplasma antigen in urine or blood, or direct detection of Histoplasma via Gomori methenamine-silver stain. Histoplasmosis-associated hemophagocytic syndrome occurs in the setting of acute disseminated histoplasmosis, which occurs in immunocompromised patients and in HIV-infected patients with CD4+ cell counts less than 200/µL. There have been 18 (including the present) cases of disseminated histoplasmosis with the hemophagocytic syndrome previously described; 12 of them occurred in HIV-infected patients (Table). CD4+ cell counts were reported in 8 of the patients, and all had CD4+ cell counts of less than 50/µL. There was an observed mortality of about 50%.

The treatment of choice for disseminated histoplasmosis is intravenous liposomal amphotericin B until the patient is afebrile and shows clinical improvement. When compared with deoxycholate amphotericin B, liposomal amphotericin B has been shown to have a higher clinical success (64% vs 88%, respectively) and less nephrotoxicity (37% vs 9%, respectively).10 Once patients are afebrile and show clinical improvement, maintenance therapy is started, usually with itraconazole. Goldman and associates11 have suggested that it may be safe to discontinue maintenance therapy if blood cultures are negative, the urinary Histoplasma antigen level is less than 4.1 units, CD4+ cell counts are greater than 150/µL, and the patient has received treatment for at least 12 months.
In summary, we have described a case of reactive hemophagocytic syndrome associated with histoplasmosis in a patient with newly diagnosed HIV/AIDS. Although the patient was in critical condition at presentation, the early identification of the fungus via peripheral blood examination allowed for the rapid implementation of treatment. Ultimately, the early identification of a causative agent, as well as the initiation of appropriate treatment, significantly contributed to his survival.
No potential conflict of interest relevant to this article was reported by the authors.
References1. Risdall RJ, McKenna RW, Nesbit ME, et al. Virus-associated hemophagocytic syndrome: a benign histiocytic proliferation distinct from malignant histiocytosis. Cancer. 1979;44:993-1002.
2. Henter JI, Elinder G, Ost A. Diagnostic guidelines for hemophagocytic lymphohistiocytosis. The FHL Study Group of the Histiocyte Society. Semin Oncol. 1991;18:29-33.
3. Grateau G, Bachmeyer C, Blanche P, et al. Haemophagocytic syndrome in patients infected with the human immunodeficiency virus: nine cases and a review. J Infect. 1997;34:219-225.
4. Kaito K, Kobayashi M, Katayama T, et al. Prognostic factors of hemophagocytic syndrome in adults: analysis of 34 cases. Eur J Haematol. 1997;59:247-253.
5. Janka G, Imashuku S, Elinder G, et al. Infection- and malignancy-associated hemophagocytic syndromes. Secondary hemophagocytic lymphohistiocytosis. Hematol Oncol Clin North Am. 1998;12:435-444.
6. Bouffandeau B, Mofredj A, Blanc S. Hemophagocytic syndrome in the critically ill. Intensive Care Med. 2001;27:948-949.
7. Rokyta R, Novak I, Matejovic M, et al. Hemophagocytic syndrome in the critically ill. Intensive Care Med. 2000;26:1712.
8. Tiab M, Mechinaud Lacroix F, Hamidou M, et al. Reactive haemophagocytic syndrome in AIDS. AIDS. 1996;10:108-111.
9. Koduri PR, Carandang G, DeMarais P, Patel AR. Hyperferritinemia in reactive hemophagocytic syndrome: report of four adult cases. Am J Hematol. 1995;49:247-249.
10. Johnson PC, Wheat LJ, Cloud GA, et al. Safety and efficacy of liposomal amphotericin B compared with conventional amphotericin B for induction therapy of histoplasmosis in patients with AIDS. Ann Intern Med. 2002;137:105-109.
11. Goldman M, Zackin R, Fichtenbaum CJ, et al. Safety of discontinuation of maintenance therapy for disseminated histoplasmosis after immunologic response to antiretroviral therapy. Clin Infect Dis. 2004;38:1485-1489.
12. Reiner AP, Spivak JL. Hematophagic histiocytosis. A report of 23 new patients and a review of the literature. Medicine (Baltimore). 1988;67:369-388.
13. Majluf-Cruz AS, Hurtado Monroy R, Souto-Meiriño C, et al. Hemophagocytic syndrome associated with histoplasmosis in the acquired immunodeficiency syndrome: description of 3 cases and review of the literature [in Spanish]. Sangre (Barc). 1993;38:51-55.
14. Keller FG, Kurtzberg J. Disseminated histoplasmosis: a cause of infection-associated hemophagocytic syndrome. Am J Pediatr Hematol Oncol. 1994;16:368-371.
15. Koduri PR, Chundi V, DeMarais P, et al. Reactive hemophagocytic syndrome: a new presentation of disseminated histoplamosis in patients with AIDS. Clin Infect Dis. 1995;21:1463-1465.
16. Chemlal K, Andrieu-Bautru V, Couvelard A. Hemophagocytic syndrome during Histoplasma capsulatum infection. Haematologica. 1997;82:726.
17. Kumar N, Jain S, Singh ZN. Disseminated histoplasmosis with reactive hemophagocytosis: aspiration cytology findings in two cases. Diagn Cytopathol. 2000;23:422-424.
18. Rao RD, Morice WG, Phyliky RL. Hemophagocytosis in a patient with chronic lymphocytic leukemia and histoplasmosis. Mayo Clin Proc. 2002;77:287-290.
19. Masri K, Mahon N, Rosario A, et al. Reactive hemophagocytic syndrome associated with disseminated histoplasmosis in a heart transplant recipient. J Heart Lung Transplant 2003;22:487-491.